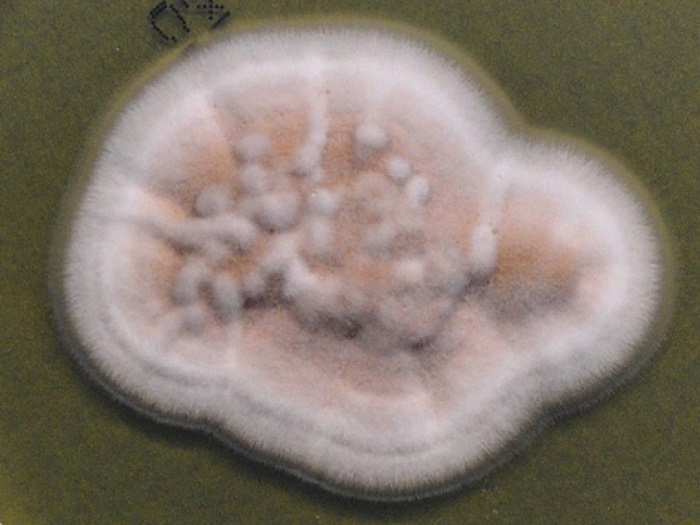

Габите се најпознати по тоа што ја враќаат мртвата органска материја во земјата, но научниците за материјали истражуваат дали еден ден можат да му помогнат и на човечкото тело да се опорави, и тоа во облик на посебни хидрогелови, пишува „Саенс алерт“ (Science alert).
За да може хидрогелот да има примена во биомедицината, мора да има повеќеслојна структура слична на онаа што ја имаат нашата кожа, ‘рскавица и мускули. Додека некои инженери се обидуваат да направат синтетички верзии кои ја имитираат биологијата, научниците од Универзитетот во Јута открија хидрогел кој буквално има „свој живот“.

Биогел добиен од габи
„Марквандомицес марквандии“/ „marquandomyces marquandii“ е вообичаен вид габа која живее во почвата и е ветувачки кандидат за оваа примена. Оваа габа помина низ мала „криза на идентитет“, бидејќи долго време беше погрешно класифицирана како „пациломицес марквандии“ /„paecilomyces marquandii, сè додека во 2020 година не го доби својот сопствен род. Наскоро, можеби ќе може да додаде и нова улога во својата биографија, како биоинтегриран хидрогел.
Таквите хидрогелови се создаваат од организми за кои знаеме дека формираат вкрстено поврзани, сложени мрежни структури, кои потенцијално можат да ги заменат нашите меки ткива.
„Хидрогеловите се сметаат за ветувачка алтернатива за примени во регенерација и инженерство на ткива, скелети за култура на клетки, биореактори и носиви уреди, благодарение на нивната способност блиску да ги имитираат вискоеластичните својства на мекото ткиво“, вели главниот автор Атул Агравал, инженер од Универзитетот во Јута, заедно со неговите колеги.
Иако најчесто ги поврзуваме габите со печурки и мувлосани наслаги, тоа се всушност нивните репродуктивни делови. Поголемиот дел од габата го сочинува мрежа од филаменти позната како мицелиум, која обично се крие длабоко во почвата, дрвото или овошјето на дното на садот. Токму таа влакнеста, слоевита мрежа ги прави габите исклучително интересен биоматеријал.
„Како што растат, габите поставуваат вкрстени ѕидови кои потоа ги делат долгите влакна на бројни поединечни клетки. Тие можат да растат бесконечно, сè додека има доволно хранливи материи… има многу во тоа однесување што би можеле да го искористиме, а што сè уште не е истражено“, објаснува микологот Брин Денингер од Природнонаучниот музеј на Јута.
Други габи веќе се тестирани како потенцијални биомедицински хидрогелови, но честопати се покажале како премногу кршливи или се сушеле премногу брзо. Тоа не беше случај со овој вид на габи, кој, кога се одгледуваше со методот на стационарна течна ферментација, создаде хидрогел способен да задржи дури 83 отсто вода.
„Она што го добивме е хидрогел со повеќе слоеви. Видлив е со голо око, а тие слоеви имаат различна порозност. Горниот слој има околу 40 отсто порозност, а потоа се менуваат појаси со 90 и 70 отсто порозност“, вели Агравал.
Истражувачите се сомневаат дека овие различни слоеви настануваат поради промените во брзината и стратегијата на раст. На пример, таму каде што габата ја достигнала површината на медиумот за раст, нејзината порозност била најмала, веројатно затоа што приоритет бил растот настрана. Тоа значи дека научниците би можеле да ги прилагодат условите за раст, како што се снабдувањето со кислород и температурата, за да ја оптимизираат микроструктурата на хидрогелот во зависност од примената.
Габите под микроскоп
„Овој вид особено беше во можност да развие големи, густи мицелиумски слоеви, што најмногу нè интересира. Мицелиумот главно се состои од хитин, слично како во лушпите на морските школки и егзоскелетите на инсектите. Биокомпатибилен е, но воедно и многу сунѓерест“, вели инженерот за материјали од Универзитетот во Јута, Стивен Налевај.
„Теоретски, би можел да се користи како шаблон за биомедицински примени или да се минерализира за да се направи потпора за коски“, додава Налевај.
Ќе помине уште доста време пред вашиот лекар да ви понуди „габична кожа“ како третман за изгореници или имплант направен од габи. „Marquandomyces marquandii“ не е штетна за луѓето, но студиите на животни укажуваат дека хитинот од мувлата може да предизвика ретки алергиски реакции.
Од друга страна, може да им помогне на некои растенија да растат. Затоа ќе бидат потребни многу повеќе експерименти за да се утврди колку добро оваа габа од почвата може да соработува со живото ткиво.
„Колку што ни е познато, ова е првиот извештај за вид на мицелиум кој постигнал хидрогелски својства во услови на потопен раст, што го позиционира ‘marquandomyces marquandii’ како нов и ветувачки материјал за биомедицински примени“, објаснил тимот истражувачи.








